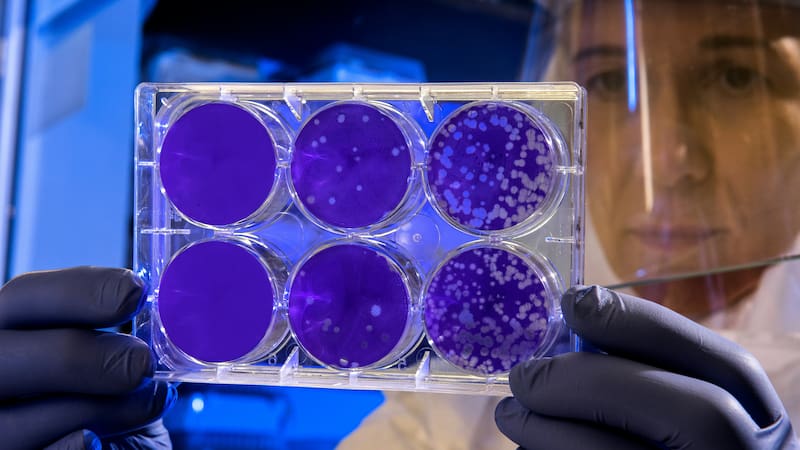

Por Cristóbal BleyEstas son las células que podrían convertirse en la cura para las enfermedades autoinmunes
El hallazgo de los linfocitos T reguladores, y del gen que los define, hizo a sus descubridores ganar este año el Premio Nobel de Medicina. ¿La razón?: su trabajo abre un nuevo camino para tratar patologías como la esclerosis múltiple y el cáncer. Expertos de la U. Andrés Bello, U. de Chile y U. Católica explican que este avance no solo transforma la comprensión del sistema inmune, sino que también permite desarrollar terapias personalizadas que podrían cambiar el pronóstico de millones de pacientes en el futuro.
Eran las 2 de la mañana del 6 de octubre y Mary Brunkow, como suele hacerlo los lunes a esa hora, estaba profundamente dormida. Cuando sonó su teléfono y en la pantalla apareció un número extraño, con un código de otro país, asumió que era una llamada spam, otra de las tantas que recibe a diario. No contestó y siguió durmiendo. Dos horas después volvió a despertarse, ahora porque su marido hablaba con alguien en el living. Todavía en pijamas, bajó a ver qué pasaba. Un periodista y un camarógrafo estaban en su casa, preguntando por ella.
“Mary”, le dijo su esposo. “Creo que has ganado el Nobel”.
Si recibir el Premio Nobel de Fisiología o Medicina 2025, galardón que compartirá con sus colegas Fred Ramsdell y Shimon Sakaguchi, resultó inesperado para Brunkow, también lo fue para el resto de la comunidad médica y científica. No porque sus descubrimientos sobre la tolerancia inmunitaria periférica no lo merezcan, sino porque normalmente la academia sueca no lo entrega a investigaciones que aún no tengan una aplicación clínica.

Durante los últimos treinta años, los tres investigadores —por separado, pero también en colaboración— lograron identificar a las células T reguladoras, las llamadas “guardias de seguridad del sistema inmunológico”, que son las que evitan que las defensas del cuerpo ataquen a nuestro propio organismo.
“Sus hallazgos han sido fundamentales para nuestra comprensión del funcionamiento del sistema inmune”, explicó Olle Kämpe, presidente del jurado del Instituto Karolinska de Estocolmo, al momento de anunciar a los nuevos nobeles. “Así como para entender por qué no todos los humanos desarrollamos enfermedades autoinmunes”.
Este último punto es el que podría traer esperanza a millones de personas que hoy sufren de patologías autoinmunes como diabetes tipo 1, lupus, esclerosis múltiple o artritis reumatoide, enfermedades crónicas que son cada vez más comunes —aumentan globalmente un 19,1% al año— y que hasta ahora tienen tratamiento, pero no una cura.

Los descubrimientos de Brunkow, Ramsdell y Sakaguchi han sido la base no sólo de un nuevo campo de investigación científica, sino además de caminos terapéuticos impensados hace unos años para las enfermedades autoinmunes.
La policía del sistema inmunológico
El pionero fue Shimon Sakaguchi, inmunólogo japonés de la Universidad de Osaka. Hasta 1995, el consenso era que el sistema inmune, para autorregularse y no atacar los tejidos propios o los componentes extraños inocuos —como los alimentos—, eliminaba a las células inmunitarias potencialmente dañinas en el timo, el órgano donde estas se originan, en un proceso llamado tolerancia central.
Pero Sakaguchi, convencido de que había algo más, ese año consiguió aislar por primera vez a las células T reguladoras (conocidas ahora como Tregs), un “subconjunto especial de linfocitos que actúa suprimiendo respuestas inmunes no deseadas”, como explica Leandro Carreño, director alterno del Instituto Milenio en Inmunología e Inmunoterapia (IMII), doctor en Ciencias Biológicas y académico de la Universidad de Chile.
Las Tregs son, como añade Claudia Riedel, investigadora asociada del IMII y profesora del Centro de Investigación de Resiliencia a Pandemias (CRP) de la Facultad de Ciencias de la Vida de la Universidad Andrés Bello, “las reguladoras del sistema inmune”, una especie de policía que, desde la periferia, reconoce qué elementos son inofensivos y disciplina al resto de las células inmunes para que no los ataquen y sean tolerantes a ellos.

El trabajo de Shimon Sakaguchi fue revolucionario, pues cambió el paradigma en la inmunología y abrió un nuevo campo de investigación. Un camino que siguieron los Premios Nobel 2025 Mary Brunkow (bióloga molecular) y Fred Ramsdell (inmunólogo), ambos estadounidenses, descubrieron el gen maestro asociado a estos linfocitos T reguladores.
Mediante un estudio con ratones que padecían una enfermedad autoinmune, identificaron en ellos “la mutación espontánea de un gen particular”, cuenta Carreño. “En 2001 lograron aislar el gen defectuoso y lo llamaron Foxp3, demostrando que dicha mutación era la causa de la enfermedad en los ratones”.
Ese mismo gen, como lo confirmaron tiempo después, también está presente en los humanos, y cuando presenta mutaciones produce síndromes relacionados con la inmunodeficiencia. Aquí es cuando las células Tregs confunden tejidos propios como amenazantes o sobrerreaccionan ante agentes externos inocuos.
“Finalmente, en 2003, Sakaguchi enlazó ambos descubrimientos cuando su grupo de investigación demostró que el gen Foxp3 es el factor indispensable que genera y define a las células T reguladoras que habían descubierto previamente”, dice el investigador de la U. de Chile.

Una luz para el cáncer y las enfermedades autoinmunes
Como se ve, lo sorpresivo del Nobel de Medicina 2025, que ni la misma Brunkow se esperaba, no tiene que ver con el nivel de las investigaciones premiadas ni la originalidad de las preguntas planteadas, sino con que todavía no cuenta con una aplicación médica concreta.
Algo que celebra Pablo González, académico de la Pontificia Universidad Católica e investigador del IMII. “Reconocer este trabajo es destacar el enorme impacto traslacional que tiene”, dice:
“Gracias a las Tregs se pueden impulsar nuevas vías terapéuticas para tratar enfermedades con componente inmunológico”.
González explica que estas células tienen “un gran potencial para suprimir respuestas inmunes no deseadas ya existentes en un individuo, tales como enfermedades autoinmunes (hay más de 100 conocidas), alergias y transplante de órganos”.

Actualmente están en desarrollo distintos tipos de inmunoterapias que buscan aumentar la frecuencia de las Tregs específicas con el fin de tratar distintas patologías. Una manera es a través de la administración de bajas dosis de una molécula inmune llamada interleuquina 2 (IL-2), que por ahora se está probando en terapias experimentales para diabetes tipo 1 y lupus.
“Por otro lado”, añade el profesor de la PUC, “existen ensayos clínicos consistentes en la transferencia adoptiva de linfocitos T reguladores”. Para ello, primero se extraen las Tregs del propio individuo, luego se expanden en el laboratorio y finalmente se reintroducen en el paciente para restaurar el equilibrio inmunológico. “Esta estrategia está siendo estudiada para tratar diabetes tipo 1, lupus, esclerosis múltiple, y artritis reumatoide, entre otros”.
Un método parecido ya se está utilizando para mejorar la tolerancia en los transplantes de órganos. Una niña española, que ahora tiene cinco años, recibió hace cuatro un transplante de corazón y fue la primera del mundo en hacerlo con un tratamiento con células T reguladoras, obtenidas desde su propio timo, órgano que normalmente se desecha en estas operaciones. Hasta ahora, su cuerpo ha manifestado muy bajos signos de rechazo.

También, como señala Claudia Riedel, académica UNAB, podrían aplicarse en el cáncer, aunque con la lógica opuesta. “En esos casos, tendríamos que lograr que el linfocito T regulador disminuya su función inhibidora y que así el sistema inmune pueda atacar las células cancerígenas”.
La dificultad, agrega Riedel, está en que estos linfocitos son específicos para reaccionar a cada enfermedad. Por lo tanto, para usarlos en tratamientos se deben separar, identificar, aislar y luego potenciar. “Pero son complejidades que muchas compañías y universidades están trabajando intensamente para desarrollar nuevas terapias. Algunos de esos estudios clínicos ya se encuentran en fase 2, o sea, con pacientes. Y les ha ido bien”.
Un Nobel de Medicina que también podría premiar en el futuro a los pacientes de enfermedades autoinmunes, hasta ahora poco acostumbrados a recibir buenas noticias.
Suscríbete a nuestro newsletter semanal, con los temas que marcan la pauta del país
COMENTARIOS
Para comentar este artículo debes ser suscriptor.
Suscríbete a nuestro newsletter semanal, con los temas que marcan la pauta del país
Lo Último
Plan digital + LT Beneficios por 3 meses
Navidad con buen periodismo, descuentos y experiencias🎄$3.990/mes SUSCRÍBETELO MÁS LEÍDO
5.




















